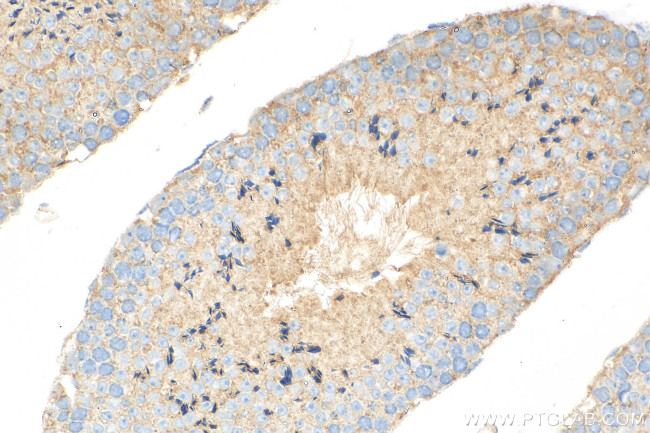
ATP8A2 Antibody in Immunohistochemistry (Paraffin) (IHC (P))

Search
Proteintech
ATP8A2 Polyclonal Antibody
{{$productOrderCtrl.translations['antibody.pdp.commerceCard.promotion.promotions']}}
{{$productOrderCtrl.translations['antibody.pdp.commerceCard.promotion.viewpromo']}}
{{$productOrderCtrl.translations['antibody.pdp.commerceCard.promotion.promocode']}}: {{promo.promoCode}} {{promo.promoTitle}} {{promo.promoDescription}}. {{$productOrderCtrl.translations['antibody.pdp.commerceCard.promotion.learnmore']}}
产品信息
31697-1-AP
种属反应
宿主/亚型
分类
类型
抗原
偶联物
形式
浓度
规格
纯化类型
保存液
内含物
保存条件
运输条件
产品详细信息
Immunogen sequence: EDVAWRAAKH TCKKTLLEEV QELETKSRVL GKAVLRDSNG KRLNERDRLI KRLGRKTPPT LFRGSSLQQG VPHGYAFSQE EHGAVSQEEV IRAYDTTKKK SRKK
靶标信息
Catalytic component of a P4-ATPase flippase complex which catalyzes the hydrolysis of ATP coupled to the transport of aminophospholipids from the outer to the inner leaflet of various membranes and ensures the maintenance of asymmetric distribution of phospholipids. Phospholipid translocation seems also to be implicated in vesicle formation and in uptake of lipid signaling molecules. Reconstituted to liposomes, the ATP8A2:TMEM30A flippase complex predomiminantly transports phosphatidylserine (PS) and to a lesser extent phosphatidylethanolamine (PE). Proposed to function in the generation and maintenance of phospholipid asymmetry in photoreceptor disk membranes and neuronal axon membranes. May be involved in vesicle trafficking in neuronal cells. Involved in regulation of neurite outgrowth; acting in synergy with TMEM30A. Required for normal visual and auditory function; involved in photoreceptor and inner ear spiral ganglion cell survival.
仅用于科研。不用于诊断过程。未经明确授权不得转售。
篇参考文献 (0)
生物信息学
蛋白别名: ATPase 8A2, class I; ATPase 8A2, p type; ATPase class I type 8A member 2; ATPase, aminophospholipid transporter, class I, type 8A, member 2; ATPase, aminophospholipid transporter-like, class I, type 8A, member 2; ATPase, class 1, member a; ML-1; P4-ATPase flippase complex alpha subunit ATP8A2; Phospholipid-transporting ATPase IB; probable phospholipid-transporting ATPase IB; unnamed protein product
基因别名: AI415030; ATP; ATP8A2; Atpc1b; ATPIB; CAMRQ4; IB; ML-1; wl
UniProt ID: (Human) Q9NTI2, (Mouse) P98200
Entrez Gene ID: (Human) 51761, (Mouse) 50769